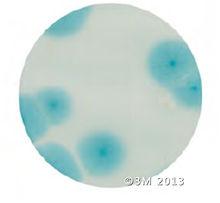
快速黴菌酵母測試片48小時的培養結果
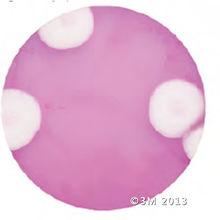
DBRC培養基5天的培養結果
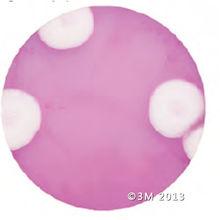
DBRC培養基5天的培養結果

背景
測試片檢測方法有操作簡單,檢測周期短等優點,它一旦投入使用,將大大縮短檢測周期,簡化實驗操作並取得較大的經濟收益,目前已被國內很多食品工廠所認可並使用。在美國前100強的80多家食品廠,都在使用 3M Petrifilm™測試片來進行微生物的檢測。
快速黴菌酵母檢測系統
黴菌和酵母的生長條件範圍很寬泛,在原料,成品和加工環境中很難控制。複雜的方法是用傳統方法培養5天。3M Petrifilm™快速黴菌酵母測試片是一種快速,簡便的方法。採用新的指示技術使菌落更容易分辨,從樣品準備到出現結果僅需48小時。
DRBC和DG-18平板法和已酸化的PDA和YGC瓊脂傾注法,這些方法的可靠性已被證實,3M™Petrifilm ™快速黴菌酵母測試片無需多個平板的接種,抗生素及酒石酸的添加,和瓊脂的準備等步驟來提高生產力。
快速結果和較少的勞動力意味著你將有更多的時間監測你的加工過程,保證嚴格的過程控制和更高質量的產品品質。
適用範圍
套用於食品和加工食品的環境樣品中。
使用方法
3M Petrifilm™快速黴菌酵母測試片的使用方法:
僅需要3步就能快速準確的測試,
1、 取1ml樣品接種測試片上,用壓板壓下
2 、在適當的溫度下培養(25℃或28℃)
3 、直接計數
特徵和優點
3M™Petrifilm™ 快速黴菌酵母測試片的特徵和優點:
l 使用方便:在接種區的周圍加有泡棉屏障,接種後壓板更容易
l 判讀方便:特有的技術可防止黴菌蔓延和重疊
l 廣泛的食品特性:能夠適用於低水分和高水分的食品
l 已證明的可靠性:vs. DRBC,DG-18,已酸化的PDA和YGC培養基方法
l 節省勞力:多層塗布技術,不再需要大量的勞力
l 用途的廣泛性:可用於空氣,塗抹和表面接觸的環境採樣
l 結果快速:新的指示劑著色技術能在48小時內指示結果
培養結果
酵母
 白地霉在優酪乳中的樣品 白地霉在優酪乳中的樣品 | 快速黴菌酵母測試片48小時的培養結果 快速黴菌酵母測試片48小時的培養結果 | DBRC培養基5天的培養結果 DBRC培養基5天的培養結果 |
黴菌
 白地霉在優酪乳中的樣品 白地霉在優酪乳中的樣品 |  快速黴菌酵母測試片48小時的培養結果 快速黴菌酵母測試片48小時的培養結果 | DBRC培養基5天的培養結果 DBRC培養基5天的培養結果 |
存放
測試片的存放:測試片我們建議在冷藏條件下存放(2~8℃),開封后的測試片應使用透明膠帶密封后,常溫、避光、乾燥保存。並在1個月內使用完。
